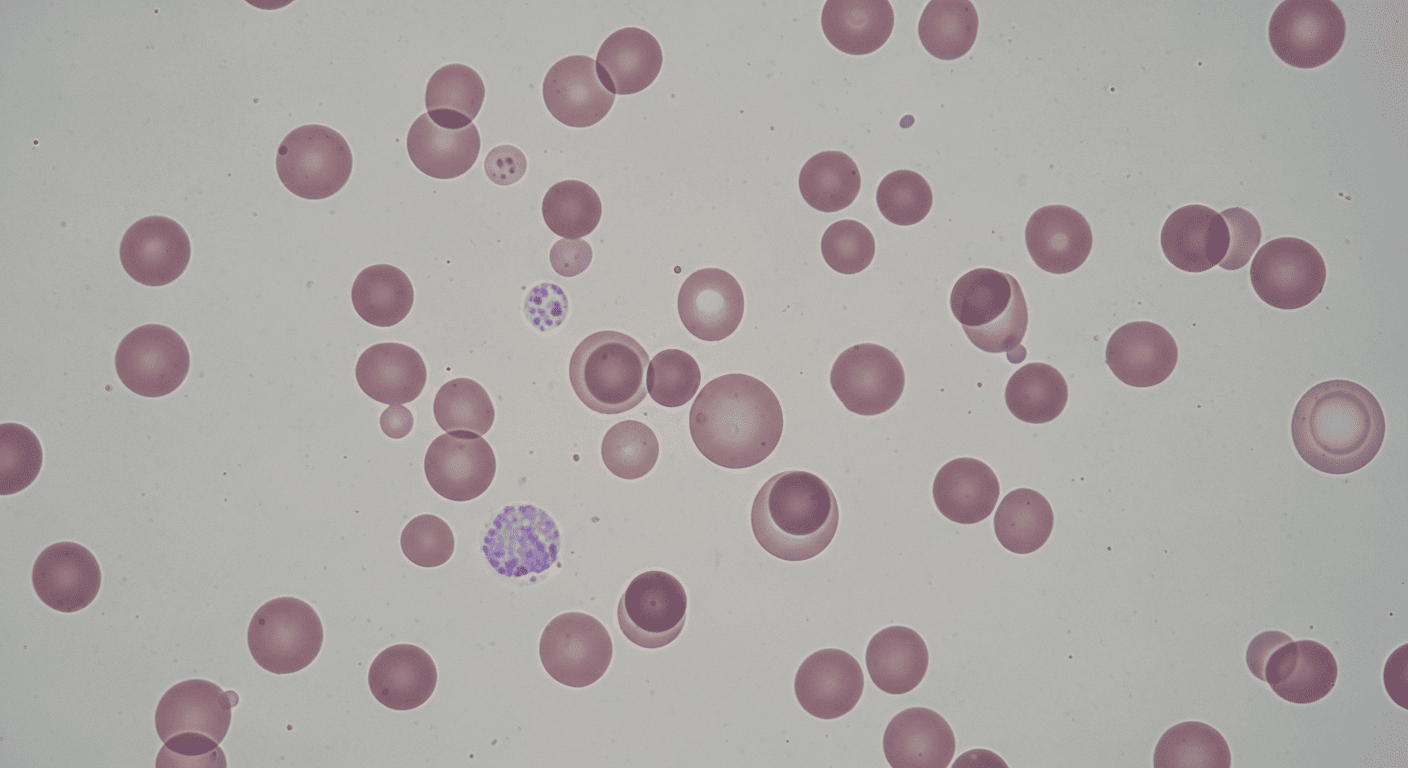
Средний объём эритроцита (MCV)

Психосоматика болезней: полная таблица органов
Какой орган связан с какой эмоцией — подробная карта психосоматических соответствий. Используйте её как навигатор по сигналам своего тела.
Читать статью
Экспертные знания о теле, психосоматике и исцелении — от практиков с опытом 20+ лет
106 статей · 6 рубрик · Обновляется еженедельно
Какой орган связан с какой эмоцией — подробная карта психосоматических соответствий. Используйте её как навигатор по сигналам своего тела.
Читать статью

Психосоматические блоки — как эмоции записываются в теле и как их освободить.

Анатомия крестца — строение, функции, роль в краниосакральной системе.

Остеопатическое лечение аденоидов у детей: альтернатива операции. Техники, результаты, показания.

Абхьянга — древний индийский масляный массаж. Техника, масла, показания, польза.

Гематокрит в анализе крови — норма, повышенный и пониженный. Что означает и что делать.

Энергетические дыры — как понять, что энергия утекает, и как восстановить поле.

Психосоматика кожи — как эмоции проявляются через экзему, псориаз, акне, дерматит.

Анатомия лёгких — строение, функции, связь с остеопатией и дыхательными техниками.

Как остеопатия помогает при головных болях и мигренях. Причины, диагностика, техники лечения. Школа здоровья ВЕСТА.

Антицеллюлитный массаж — работает ли? Научный взгляд, техники, реальные результаты.

Гемоглобин — что это, нормы для мужчин и женщин, причины повышения и снижения.

Интуиция — это навык, а не дар. Практические методы развития интуиции от специалистов Школы ВЕСТА.

Почему врачи ничего не находят, а боль остаётся? Психосоматика объясняет связь между эмоциями и физическими симптомами.

Анатомия печени — строение, функции, висцеральная остеопатия. Главная лаборатория организма.

Остеопатия для новорождённых — безопасные мягкие техники для младенцев. Показания, противопоказания, когда обращаться....

История, техника и эффект японского массажа Кобидо — натуральная альтернатива инъекционному омоложению лица.

Гранулоциты в анализе крови — нейтрофилы, эозинофилы, базофилы. Норма и отклонения.

Почему давление повышается в конфликтах и как эмоциональная работа помогает его нормализовать. Психосоматический взгляд...

Анатомия сердца — строение, функции, связь с остеопатией. Как устроен главный орган.

Сравнение остеопатии и хиропрактики: подход, техники, показания, результаты. Что выбрать?

Мексиканская техника обёртывания тела ребозо — чем она уникальна, как работает и почему набирает популярность среди...

МСНС — средняя концентрация гемоглобина в эритроците. Что показывает, нормы, отклонения.

Телесно-ориентированная психотерапия — что это, как работает, кому подходит. Полный гид.

Боль в пояснице — причины, диагностика, лечение. Когда к врачу, когда к остеопату, когда пройдёт сама.

Как выбрать хорошего остеопата: образование, опыт, подход. 7 критериев, на которые стоит обратить внимание.

Триггерные точки — что это, как найти, как убрать. Самомассаж и профессиональные техники.

Лейкоциты в анализе крови — норма, лейкоцитоз, лейкопения. Что означает повышение и снижение.

Исцеление внутреннего ребёнка — как детские травмы живут в теле взрослого и как их отпустить.

Грудной остеохондроз — симптомы, которые маскируются под болезни сердца и лёгких. Диагностика и лечение.

Что такое краниосакральная терапия, как она работает, кому подходит и с чего начать обучение — полный гид для...

Векторный массаж — современная техника работы с фасциями и мышечными цепями.

Лимфоциты в крови — T-клетки, B-клетки, NK-клетки. Норма и что означают отклонения.

Грыжа Шморля — что это, опасно ли, нужно ли лечить. Остеопатический подход.

Остеопатический лимфодренаж — мягкая техника улучшения оттока лимфы. Показания, техника, результаты.

Моноциты в анализе крови — функции, норма, моноцитоз. Что означает повышение.

Практические техники, которые помогут восстановить контакт с телом и заметить его сигналы вовремя. Учимся слышать себя.

Как остеопатия помогает при логопедических проблемах у детей: речевые задержки, дизартрия, заикание.
MCV — средний объём эритроцита. Что показывает, нормы, микроцитоз и макроцитоз.

Все способы лечения остеохондроза: от таблеток до остеопатии. Что работает, а что — нет.

Остеопатическое лечение мигрени: механизм, техники, результаты. Альтернатива таблеткам.

RDW — ширина распределения эритроцитов. Что показывает анизоцитоз, нормы.

Оргонотерапия — телесно-ориентированная терапия Райха. Мышечный панцирь, 7 сегментов, техники.

Можно ли освоить остеопатические техники без диплома врача — честный разбор возможностей, ограничений и путей обучения.

MCH — среднее содержание гемоглобина в одном эритроците. Норма и отклонения.

Остеохондроз — что это, почему возникает, как лечить. Остеопатический взгляд на самый частый диагноз.

Реальные отзывы о лечении остеопатией: при каких проблемах помогает, сколько нужно сеансов, чего ожидать.

Тромбоциты в анализе крови — норма, тромбоцитоз, тромбоцитопения. Что означает.

Пояснично-крестцовый остеохондроз: причины, симптомы, лечение. Почему болит поясница и что делать.

Полный список показаний к остеопатическому лечению: от болей в спине до проблем у новорождённых.

7 главных причин остеохондроза и дегенерации позвоночника. Что убивает ваши диски.

4 основных принципа остеопатии Эндрю Стилла: тело как единое целое, самоисцеление, структура и функция.

Научные и практические основы самовосстановления организма — как тело исцеляет себя и что мы можем сделать, чтобы ему...

Стоимость приёма остеопата в России: от чего зависит цена, сколько сеансов нужно, как сэкономить.

Шейный остеохондроз — причины, симптомы, лечение без операции. Остеопатический подход.

Остеопатическое лечение суставов: артроз, артрит, боли в коленях и плечах. Мягкие техники без операции.

Строение тела человека — системы, органы, ткани. Обзор для начинающих телесных практиков.

10 остеопатических упражнений для самостоятельной практики: шея, спина, диафрагма, таз.

Семь телесных сигналов хронического стресса, которые мы чаще всего игнорируем. Учимся распознавать и реагировать...

Мышечные зажимы — это память тела о пережитом стрессе. Как их распознать, что они означают и как от них избавиться.

Введение в психосоматику: как связаны тело и эмоции, почему болезни не случайны и как научиться читать сигналы организма.

Почему «не перевариваю» — не метафора. Как подавленные эмоции влияют на пищеварительную систему.

Сердце и лёгкие — органы связи и любви. Как эмоциональные раны отражаются на сердечно-сосудистой и дыхательной системе.

Связь мочеполовой системы с темами безопасности, территории, сексуальности и творчества.

Головные боли, проблемы со зрением и слухом — что тело пытается вам сказать через органы чувств.

Нервная система — дирижёр тела. Как хронический стресс нарушает регуляцию и к чему это приводит.

Кожа — граница между мной и миром. Экзема, псориаз, аллергия — как тело говорит о нарушенных границах.

Иммунная и эндокринная системы — зеркало внутренней безопасности. Как эмоции влияют на защитные силы организма.

Как психологическое состояние матери влияет на течение беременности и здоровье ребёнка.

Четыре матрицы рождения по Станиславу Грофу — как опыт появления на свет формирует всю дальнейшую жизнь.

Ноги и таз — опора и движение. Как страх перемен и потеря устойчивости проявляются в теле.

Руки — действие и контакт. Шея — связь головы и тела. Что значат боли и зажимы в этих зонах.

Позвоночник — ось жизни. Каждый отдел связан с определённой темой: от выживания до духовности.

Как телесные зажимы блокируют финансовый поток и какие паттерны тела связаны с денежными установками.

Почему болит шея, если на МРТ «всё чисто»? Разбираем 6 скрытых причин хронической боли в шейном отделе.

Боль в пояснице после 8 часов за столом. Биомеханика сидения, роль таза и техники самопомощи.

Как связаны шейный и поясничный отделы позвоночника. Биомеханика, компенсации и системный подход.

Скрытые причины боли в коленях: мышечный дисбаланс, стопы, таз. Почему ортопед не видит главного.

Причины онемения пальцев: от синдрома запястного канала до лестничных мышц шеи.

Мышечные причины тяжести в ногах: фасции, лимфа, таз. Техники самопомощи.

Причины боли между лопатками: грудной отдел, рёбра, диафрагма, внутренние органы.

Связь грудного отдела, диафрагмы и внутренних органов. Остеопатический подход.

Спазм диафрагмы и ригидность грудной клетки. Как восстановить глубокое дыхание.

Анатомия миофасциальных цепей и как они создают отражённую боль по всему телу.

Механизм хронического гипертонуса, последствия и остеопатические методы коррекции.

Мягкая техника работы с соединительной тканью. Показания и отличия от массажа.

Работа с внутренними органами через переднюю стенку живота. Как работает, какие проблемы решает.

Висцероптоз — причина хронической усталости и тазовых болей. Диагностика и коррекция.

Работа с кишечником, диафрагмой и нервной системой. Почему слабительные не решают проблему.

Хроническое мышечное напряжение и подавленные эмоции. 7 сегментов Райха и методы работы.

Сколиоз, сутулость, кифоз у детей — остеопатический подход к диагностике и мягкой коррекции.

Биомеханика осанки, роль стоп и таза, мышечный панцирь и формирование свободного тела.

Почему остеохондроз есть у всех, а болит не у всех. Остеопатический взгляд на боль в шее.

Причины холки: гормоны, осанка, грудной отдел. Как убрать остеопатическими методами.

Цервикогенное головокружение — когда шея «врёт» мозгу. Диагностика и остеопатическое лечение.

Работа с 22 костями черепа для лечения головных болей, ВНЧС, бессонницы и стресса.

Работа с костями черепа, мимическими мышцами и лимфой. Альтернатива инъекциям.

Причины, последствия и остеопатическое лечение бруксизма. Почему капы не решают проблему.

Что на самом деле происходит при «смещении» и как корректировать мягко, без хруста.

Альтернатива жёстким мануальным трастам. Почему мягкие техники эффективнее и безопаснее.

Почему массаж и мануальная терапия вредят при нестабильности. Остеопатическая стабилизация.

Механизм психосоматической боли: как стресс и подавленные эмоции превращаются в реальные телесные ощущения.

Природа внутреннего критика и как перестать жить в режиме вечной самооценки.

5 стадий выгорания, телесные проявления и путь назад — без таблеток и «позитивного мышления».

Авторская философия Сергея Сапожникова о возвращении к ясности, опоре и зрелому проживанию жизни.

Парадокс гиперконтроля: почему попытка всё удержать приводит к потере себя и здоровья.
Подпишитесь — и мы пришлём бесплатный материал и лучшие статьи раз в месяц
Никакого спама. Только полезные материалы.